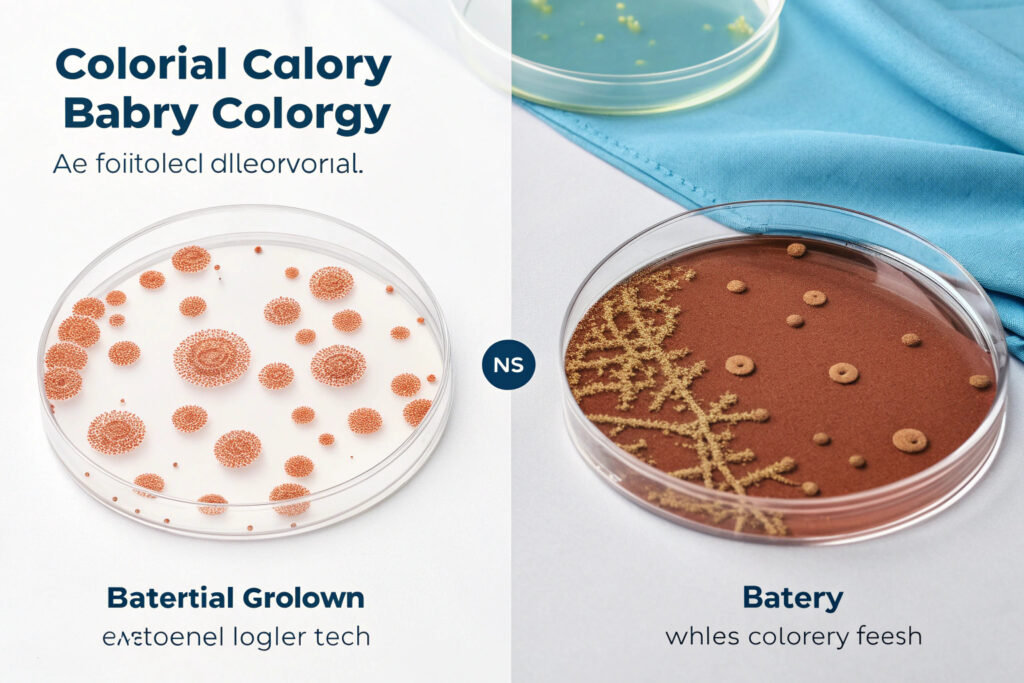

If you're a fitness brand or retailer, you know that the modern gym-goer is looking for more than just a sweatband. They expect gear that performs, stays fresh, and supports their overall wellness. However, the warm, humid microclimate inside a gym cap is a perfect breeding ground for odor-causing bacteria, leading to products that degrade quickly in both performance and perceived value. This creates a clear pain point: how do you deliver a premium product that maintains its integrity and appeal through intense, repeated use?
The answer lies in intelligent material innovation, and copper-infused liners offer a scientifically-backed solution. By integrating copper at the molecular level, these fabrics deliver powerful, lasting antimicrobial action directly where it's needed most. This isn't a surface treatment; it's a fundamental enhancement that protects the product, enhances the user experience, and provides a compelling marketing story. For brands like yours, it translates into a higher-quality product that commands a premium and builds lasting customer loyalty.
Let's examine the concrete benefits this technology brings to the table and why it's becoming a non-negotiable feature for performance headwear.
How Do Copper-Infused Fabrics Combat Gym Hygiene Issues?
The core challenge with any gym wear is managing the biological byproducts of a great workout: sweat, heat, and bacteria. Standard fabrics trap moisture, allowing odor-causing bacteria like Staphylococcus aureus and Escherichia coli to thrive. This leads to the familiar, stubborn stench that washing doesn't always eliminate, shortening the garment's functional life and making it unpleasant to wear.
Copper-infused liners tackle this problem at its source with continuous and automatic antimicrobial action. Unlike temporary sprays or coatings that wash out, copper ions are integrated into the fibers themselves. When microbes come into contact with the fabric, the copper ions disrupt their cellular processes, effectively killing them. Studies show that copper alloys can eliminate over 99.9% of bacteria within hours. For a gym cap, this means the inner band—the part in constant contact with sweaty skin—actively resists bacterial growth, drastically reducing odor between washes and maintaining a fresher feel for longer.
What is the Scientific Mechanism Behind the Antimicrobial Action?
The effectiveness isn't magic; it's rooted in electrochemistry. Copper ions (Cu⁺ and Cu⁺⁺) carry a positive charge. Bacterial and fungal cell membranes are typically negatively charged. This creates an attractive force, drawing the copper ions to the microbes.
Upon contact, the ions penetrate the cell wall and wreak havoc inside in several key ways:
- They bind to enzymes, crippling the cell's ability to breathe and process nutrients.
- They generate reactive oxygen species (ROS), which are highly destructive molecules that cause oxidative damage to the cell's interior.
- They interfere with the cell's DNA, preventing it from replicating properly.
This multi-pronged attack is why bacteria struggle to develop resistance to copper, making it a robust and reliable solution. A 2017 patent details how integrating copper during the fiber spinning process creates a uniform and lasting distribution, ensuring the effect persists through countless washes and the lifespan of the garment. This is a crucial advantage over surface finishes that degrade.
How Does This Extend Beyond Odor to General Wearer Wellness?
The benefits extend past just smell. A cleaner cap liner means a reduced risk of minor skin irritations, folliculitis, or acne that can be exacerbated by dirty gear. For athletes, especially professionals, avoiding illness is critical. As highlighted by the Canadian Sport Institute Ontario, the use of antimicrobial copper on high-touch gym equipment provides athletes with "peace of mind" by adding an extra layer of protection against germs in shared spaces. While a hat liner is a personal item, the same principle applies: it minimizes the user's exposure to their own accumulated microbes, supporting overall skin health and hygiene. This proactive wellness feature is a strong selling point for health-conscious consumers.
What Performance Advantages Do Copper-Infused Liners Offer?
Beyond hygiene, modern athletes demand gear that enhances their physical experience. Performance is measured in comfort, temperature regulation, and durability. Copper-infused fabrics contribute here as well, moving the product from a passive accessory to an active component of the workout.
The primary performance advantage is superior moisture management and thermal regulation. Copper is an excellent conductor of heat. When integrated into fibers, it helps distribute body heat more evenly and can accelerate the evaporation of sweat. Some advanced fibers, like COPPRON®, are engineered not only with copper but also with hydrophilic (water-attracting) groups, giving them a high moisture regain rate similar to cotton. This combination wicks moisture away from the skin faster than standard synthetic liners, keeping the wearer cooler, drier, and more comfortable during intense activity. For a gym cap, this translates to less sweat dripping into the eyes and a more comfortable fit.

Can This Technology Truly Enhance Comfort and Longevity?
Absolutely. The comfort benefits are direct:
- Dryness: Faster evaporation means the liner feels less soggy.
- Temperature: Better heat distribution prevents the "hot spot" feeling on the forehead.
- Skin Health: A less microbial environment reduces the chance of itchiness or irritation from prolonged wear.
In terms of longevity, the advantages are equally clear. Odor is a primary reason consumers discard athletic wear. By structurally inhibiting bacterial growth, copper-infused fabrics prevent the permanent embedding of odor molecules in the fibers. This means the cap stays fresher and more like new for dozens more washes. Furthermore, the integration of copper at the polymer stage, as seen in patented technologies, ensures these properties are durable and wash-resistant, not a temporary treatment that fades. This directly supports sustainability by extending the product's usable life, a key concern for modern brands and consumers.
What About Claims for Enhanced Recovery and Performance?
It's important to differentiate between proven and speculative benefits. While some brands marketing copper compression gear imply direct benefits for muscle recovery and performance, a 2017 scholarly review noted a lack of robust scientific literature specifically supporting these enhanced claims for copper-infused clothing. The review suggested that benefits are likely attributable to the compression aspect rather than the copper itself.
For gym caps, the performance claim is more straightforward and defendable: creating a drier, more hygienic, and comfortable microclimate allows the athlete to focus on their training without distraction. This indirect support of performance through improved comfort and wellness is a credible and powerful narrative for brands like Shanghai Fumao Clothing to communicate, avoiding the need for unsubstantiated claims.
Why is This a Strategic Move for Brands and Manufacturers?
In a crowded market, differentiation is key. Copper-infused technology offers a tangible, functional upgrade that can be clearly communicated and verified. It moves a product from a commodity to a specialized performance item, justifying a higher price point and building brand reputation for innovation.
From a brand perspective, it addresses multiple consumer drivers:
- The Wellness Trend: Tapping into the proactive health and hygiene market.
- Performance Demand: Meeting expectations for technical, functional apparel.
- Sustainability: Promoting product longevity by fighting odor-based degradation.
- Value Perception: Offering a visible, "smart" feature that enhances daily use.

How Does This Integrate into Modern Manufacturing and Sourcing?
For a manufacturer, incorporating this technology is increasingly feasible. Advanced functional fibers like copper-ion acrylic (e.g., COPPRON) or copper-embedded polyester are available as raw materials for sourcing. The key for a production partner is expertise in working with these technical materials—understanding their dyeing requirements (they can be sensitive to strong acids or alkalis) and construction techniques to maximize the benefit.
Partnering with a specialist like Shanghai Fumao Clothing ensures that the technology is correctly integrated from the fabric sourcing stage. Our experience with functional materials and CNAS-accredited lab testing allows for validation of the antimicrobial claims, providing you with the data needed for marketing and consumer trust. We can manage the entire process, from selecting the right copper-infused fabric blend to producing finished caps that reliably deliver on the promised benefits.
What is the Market Potential and Consumer Reception?
The market is ready. Consumers have been introduced to copper's benefits in other areas, from antimicrobial hospital surfaces to copper-coated gym equipment endorsed by high-performance institutions. This creates a foundation of awareness that brands can build upon. Positioning a gym cap with this technology isn't about introducing a radical unknown; it's about applying a proven, trusted solution to a new, everyday problem.
For the end-user, the value proposition is simple: a hat that stays fresher, feels better, and lasts longer. It solves a genuine annoyance with a scientifically sound solution. For you, the brand, it represents an opportunity to lead in a niche, command better margins, and foster loyalty with customers who appreciate genuine innovation that improves their daily routine.
Can Copper-Infused Liners Address Core Comfort Needs During Workouts?
Comfort is a primary requirement for gym caps, and copper-infused liners excel in meeting this demand through their special material characteristics.
During intense workouts, the body produces a great deal of sweat, which, if not absorbed and evaporated in time, can accumulate on the scalp and forehead, causing discomfort such as stickiness and itching. Copper-infused liners have excellent moisture-wicking capabilities; the copper ions integrated into the fabric can accelerate the transfer of sweat from the skin surface to the outer layer of the cap, allowing it to evaporate quickly.

Does Copper-Infused Material Effectively Combat Gym Cap Odor?
One of the most troublesome issues with gym caps is the accumulation of odor after repeated use. This odor is mainly caused by the reproduction of bacteria that thrive in the warm, humid environment created by sweat.
Copper-infused liners solve this problem by leveraging the natural antibacterial properties of copper ions.
Can Copper-Infused Liners Provide Additional Scalp Protection During Workouts?
During workouts, the scalp is exposed to various potential stimuli, such as friction from the cap, sweat irritation, and even UV rays when exercising outdoors.
Copper-infused liners offer additional protection for the scalp beyond basic sweat absorption, providing a multi-layered defense against common scalp irritations and environmental stressors. Infused with microscopic copper ions, these liners work to neutralize bacteria that can thrive in damp, sweaty conditions, reducing the risk of odor and potential scalp infections.
Conclusion
Copper-infused liners are crucial for gym caps because they solve fundamental problems of hygiene, comfort, and durability with a scientifically validated approach. They transform a basic accessory into a high-performance gear item by actively fighting odor-causing bacteria, improving moisture management, and extending the product's functional life. This technology provides a clear and marketable point of differentiation that aligns perfectly with contemporary consumer values around wellness, performance, and value.
In an industry where details make the difference, this is a detail that matters. It's an investment in product quality that pays dividends in customer satisfaction and brand perception.
If you are looking to develop a cutting-edge line of performance headwear that stands out in the market, let's discuss how to integrate copper-infused technology into your designs. For a detailed conversation on sourcing, development, and production, please contact our Business Director, Elaine. She and her team at Shanghai Fumao Clothing are ready to help you build a superior product. You can reach her at: elaine@fumaoclothing.com.